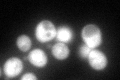
YPR069C
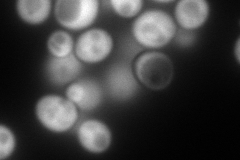
YPR069C
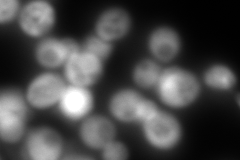
YPR069C
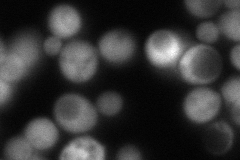
YPR069C
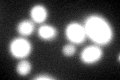
YPR069C
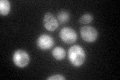
YPR069C

View description
Spermidine synthase, involved in biosynthesis of spermidine and also in biosynthesis of pantothenic acid; spermidine is required for growth of wild-type cells
Localization:
Intensity:
Fold change:
Significance:
-
C’ GFP library in SD
cytosol127.35 -
N' NOP1pr-GFP in SD
cytosol395.03 -
N' TEF2pr-mCherry in SD
cytosol18.1656 -
N' NATIVEpr-GFP in SD
cytosol120.544 -
N' TEF2pr-VC and Cyto-VN in SD

#N/A0 -
C’ GFP library in SD+DTT
cytosol91.370.71No -
C’ GFP library in SD+H2O2

cytosol126.80.99No -
C’ GFP library in Starvation Media
cytosol97.140.76No -
C’ GFP library on the background of Pup2-DaMP

cytosol -
C’ GFP library on the background of CCT mutant

cytosol98.85860.776201No
